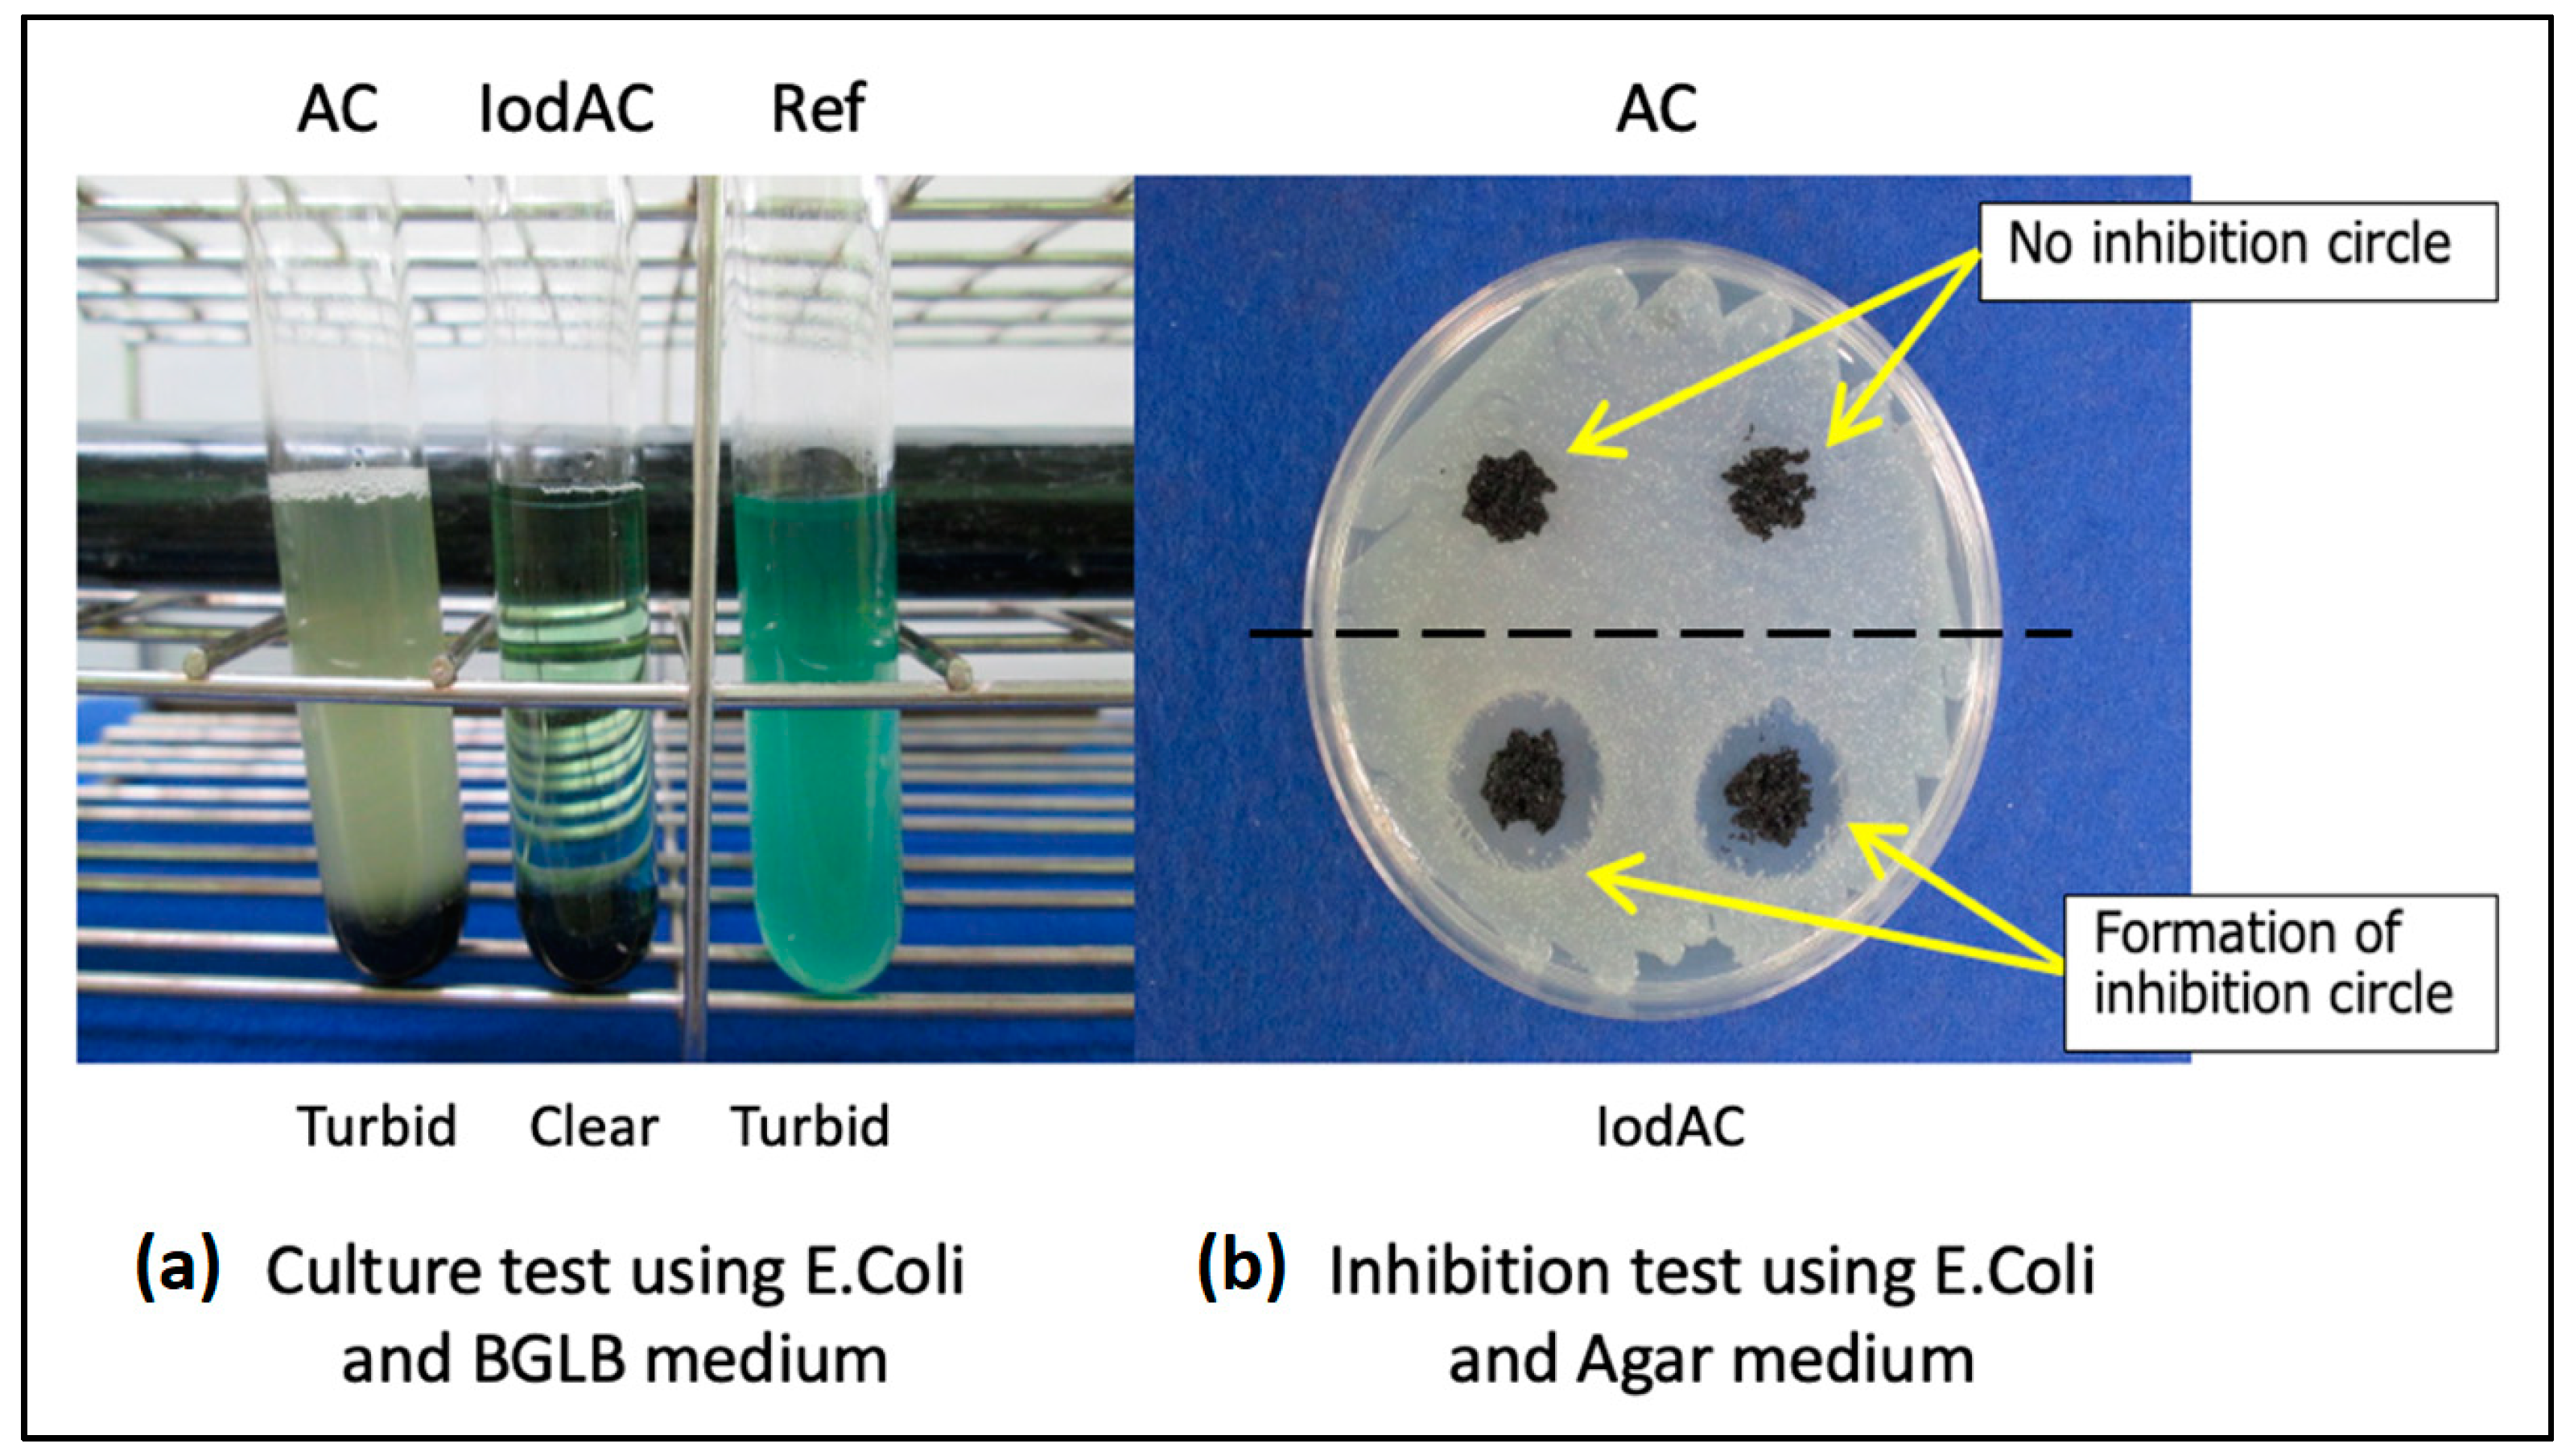
Carbon 07 00086 g006 550

Activated Carbon Impregnated with Elementary Iodine: Applications against Virus- and Bacteria-Related Issues
Abstract
:1. Introduction
2. Materials and Methods
2.1. IodAC Production
2.2. IodAC Characterization
2.3. Skin Compatibility and Staining Test
2.4. Antibacterial Test
2.5. Antiviral Test
2.6. Use as a Disinfectant for Drinking Water
2.7. Use as a Granular Disinfectant for Public Spaces and Livestock Farming
3. Results
3.1. Skin Compatibility and Staining Test Results
3.2. Antibacterial Test Results
3.3. Antiviral Test Results
3.4. Use as a Disinfectant for Drinking Water
3.5. Use as a Granular Disinfectant for Public Spaces and Livestock Farming
3.6. Other Application Possibilities
4. Conclusions
Author Contributions
Funding
Institutional Review Board Statement
Informed Consent Statement
Data Availability Statement
Conflicts of Interest
References
- Roy, A.; Parida, S.P.; Bhatia, V. Role of disinfection and hand hygiene: A COVID-19 perspective. Int. J. Community Med. Public Health 2020, 7, 2845–2849. [Google Scholar] [CrossRef]
- Hirose, R.; Bandou, R.; Ikegaya, H.; Watanabe, N.; Yoshida, T.; Daidoji, T.; Naito, Y.; Itoh, Y.; Nakaya, T. Disinfectant effectiveness against SARS-CoV-2 and influenza viruses present on human skin: Model-based evaluation. Clin. Microbiol. Infect. 2021, 27, 1042.e1–1042.e4. [Google Scholar] [CrossRef] [PubMed]
- Lichtenstein, D.; Alfa, M.J. Cleaning and Disinfecting Gastrointestinal Endoscopy Equipment. In Clinical Gastrointestinal Endoscopy, 3rd ed.; Chandrasekhara, V., Elmunzer, B.J., Khashab, M., Muthusamy, V.R., Eds.; Elsevier: Amsterdam, The Netherlands, 2019; pp. 32–50. [Google Scholar]
- Vasudevan, P.; Tandon, M. Antimicrobial properties of iodine based products. J. Sci. Ind. Res. 2010, 69, 376–383. [Google Scholar]
- Kaiho, T. Iodine Chemistry and Applications, 1st ed.; Kaiho, T., Ed.; John Wiley & Sons, Inc.: Hoboken, NJ, USA, 2015; pp. 15–410. [Google Scholar]
- Supriya, P.; Priya, N.; Harpal, S.; Padma, V. Iodine based water disinfection: A review. J. Sci. Ind. Res. 2006, 65, 116–120. [Google Scholar]
- Eggers, M. Infectious Disease Management and Control with Povidone Iodine. Infect. Dis. Ther. 2019, 8, 581–593. [Google Scholar] [CrossRef] [Green Version]
- Selvaggi, G.; Monstrey, S.; Van Landuyt, K.; Hamdi, M.; Blondeelet, P.H. The role of iodine in antisepsis and wound management: A Reappraisal. Acta Chir. Belg. 2003, 103, 241–247. [Google Scholar] [CrossRef]
- Zhao, G.; He, C.; Zhou, W.; Hooper, J.P.; Imler, G.H.; Parrish, D.A.; Shreeve, J.M. Control of Biohazards: A High Performance Energetic Polycyclized Iodine-Containing Biocide. Inorg. Chem. 2018, 57, 8673–8680. [Google Scholar] [CrossRef]
- Wang, S.; Schoenitz, M.; Grinshpun, S.A.; Yermakov, M.; Dreizin, E.L. Biocidal effectiveness of combustion products of iodine-bearing reactive materials against aerosolized bacterial spores. J. Aerosol Sci. 2018, 116, 106–115. [Google Scholar] [CrossRef]
- Khalkhali, R.A.; Omidvari, R. Adsorption of Mercuric Ion from Aqueous Solutions Using Activated Carbon. Pol. J. Environ. Stud. 2005, 14, 185–188. [Google Scholar]
- Rowe, N.R. Odor Control with Activated Charcoal. J. Air Pollut. Control Assoc. 1963, 13, 150–153. [Google Scholar] [CrossRef]
- Sekimoto, S.; Tatenuma, K.; Suzuki, Y.; Tsuguchi, A.; Tanaka, A.; Tadokoro, T.; Kani, Y.; Morikawa, Y.; Yamamoto, A.; Ohtsuki, T. Separation and purification of 99mTc from 99Mo produced by electron linear accelerator. J. Radioanal. Nucl. Chem. 2017, 311, 1361–1366. [Google Scholar] [CrossRef]
- Mumford, K.A.; Churchill, J.G. Granular Activated Carbon in Water Treatment. In Pure and Functionalized Carbon-Based Nanomaterials; CRC Press: Boca Raton, FL, USA, 2020. [Google Scholar]
- Park, J.E.; Lee, G.B.; Hong, B.U.; Hwang, S.Y. Regeneration of Activated Carbons Spent by Waste Water Treatment Using KOH Chemical Activation. Appl. Sci. 2019, 9, 5132. [Google Scholar] [CrossRef] [Green Version]
- Chen, W.; Parette, R.; Zou, J.; Cannon, F.S.; Dempsey, B.A. Arsenic removal by iron-modified activated carbon. Water Res. 2007, 41, 1851–1858. [Google Scholar] [CrossRef] [PubMed]
- Sultan, A.; Rafar, M.; Ahsan, A. Nitrogen doped activated carbon derived from orange peel for supercapacitor application. Adv. Nat. Sci. Nanosci. Nanotechnol. 2018, 9, 035338. [Google Scholar]
- Lizhi, H.; Guoqiao, W.; Xinxin, Z.; Yujian, Z.; Yao, C. Lanthanum-doped activated carbon derived from municipal sludge for enhanced defluoridation: Characteristics and mechanism. Water Sci. Technol. 2020, 82, 1643–1652. [Google Scholar]
- Velasco, L.F.; Kim, K.H.; Lee, Y.S.; Lodewyckx, P. Influence of Fluorine Doping of Activated Carbon Fibers on Their Water Vapor Adsorption Characteristics. Front. Chem. 2021, 8, 593756. [Google Scholar] [CrossRef] [PubMed]
- Tsai, C.; Hsu, H.; Lin, C. Treatment of chronic wounds with the silver-containing activated carbon fiber dressing: Three cases. J. Med. Cases 2014, 5, 587–591. [Google Scholar] [CrossRef]
- Burchacka, E.; Pstrowska, K.; Beran, E.; Fałtynowicz, H.; Chojnacka, K.; Kułażyński, M. Antibacterial Agents Adsorbed on Active Carbon: A New Approach for S. aureus and E. coli Pathogen Elimination. Pathogens 2021, 10, 1066. [Google Scholar] [CrossRef]
- Petuhov, O.; Lupascu, T.; Behunová, D.; Povar, I.; Mitina, T.; Rusu, M. Microbiological Properties of Microwave-Activated Carbons Impregnated with Enoxil and Nanoparticles of Ag and Se. C 2019, 5, 31. [Google Scholar] [CrossRef] [Green Version]
- Moon, H.; Lee, Y.-C.; Hur, J. One-Pot Decoration of Cupric Oxide on Activated Carbon Fibers Mediated by Polydopamine for Bacterial Growth Inhibition. Materials 2020, 13, 1158. [Google Scholar] [CrossRef] [Green Version]
- Kumar, T.K.M.P.; Mandlimath, T.R.; Sangeetha, P.; Sakthivel, P.; Revathi, S.K.; Kumar, S.A.; Sahoo, S.K. Highly efficient performance of activated carbon impregnated with Ag, ZnO and Ag/ZnO nanoparticles as antimicrobial materials. RSC Adv. 2015, 5, 108034–108043. [Google Scholar] [CrossRef]
- Acevedo, S.; Arevalo-Fester, J.; Galicia, L.; Atencio, R.; Plaza, E.; Gonzalez, E. Effciency Study of Silver Nanoparticles (AgNPs) Supported on Granular Activated Carbon against Escherichia coli. J. Nanomed. Res. 2014, 1, 1–5. [Google Scholar]
- Srinivasan, N.R.; Shankar, P.A.; Bandyopadhyaya, R. Plasma treated activated carbon impregnated with silver nanoparticles for improved antibacterial effect in water disinfection. Carbon 2013, 57, 1–10. [Google Scholar] [CrossRef]
- Wang, W.; Xiao, K.; He, T.; Zhu, L. Synthesis and characterization of Ag nanoparticles decorated mesoporous sintered activated carbon with antibacterial and adsorptive properties. J. Alloy. Compd. 2015, 647, 1007–1012. [Google Scholar] [CrossRef]
- Spaziani, F.; Natori, Y.; Kinase, Y.; Kawakami, T.; Tatenuma, K. Elementary Iodine-Doped Activated Carbon as an Oxidizing Agent for the Treatment of Arsenic-Enriched Drinking Water. Water 2019, 11, 1778. [Google Scholar] [CrossRef] [Green Version]
- Otsuki, K.; Takemoto, O.; Fujimoto, R.; Yamazaki, K.; Kubota, T.; Hosaki, H.; Mitani, T.; Kawaoka, Y.; Tsubokura, M. Isolation of H5 influenza viruses from whistling swans in western Japan in November 1983. Acta Virol. 1984, 28, 524. [Google Scholar]
- Otsuki, K.; Takemoto, O.; Fujimoto, R.; Yamazaki, K.; Kubota, N.; Hosaki, H.; Mitani, T.; Tsubokura, M. Isolation of influenza A viruses from migratory waterfowl in San-in District, western Japan in the winter of 1983–1984. Res. Vet. Sci. 1987, 43, 177–179. [Google Scholar] [CrossRef]
- Reed, L.J.; Muench, H. A simple method of estimating fifty percent endpoints. Am. J. Hyg. 1938, 27, 493–497. [Google Scholar]
- Swayne, D.E. Avian influenza. In Foreign Animal Diseases; United States Animal Health Association: Boca Raton, FL, USA, 2008; pp. 137–146. [Google Scholar]
- Killian, M.L. Avian influenza virus sample types, collection, and handling. Methods Mol Biol. 2014, 1161, 83–91. [Google Scholar]

| Properties | IodAC |
|---|---|
| Color, form | Black, granular |
| Granular size | 0.25–0.5 mm |
| Bulk density | 0.50–0.56 g/cc |
| Element composition | Carbon (C), Iodine (I), Oxygen (O) |
| Heat resistance | 184 °C (I2 gradually volatile at higher temperature) |
| Weight loss by drying | ≤5.0% |
| pH | 4.0–6.0 |
| Chemical durability | Strong in 2–5% acids, alcohol, organic solvents Weak in highly concentrated alkali, alcohol, organic solvents, reductants |
| Impregnated iodine amount | I2 30 g/AC 100 g |
| Corrosion rate | <0.01 mmpy (SUS316 in seawater) |
| Solubility in water | Iodide (I−) < 0.05%; elementary iodine (I2) < 0.05% |
| Ash | ≤2.0% |
Publisher’s Note: MDPI stays neutral with regard to jurisdictional claims in published maps and institutional affiliations. |
© 2021 by the authors. Licensee MDPI, Basel, Switzerland. This article is an open access article distributed under the terms and conditions of the Creative Commons Attribution (CC BY) license (https://creativecommons.org/licenses/by/4.0/).
Share and Cite
Natori, Y.; Kinase, Y.; Ikemoto, N.; Spaziani, F.; Kojima, T.; Kakuta, H.; Fujita, J.; Someya, K.; Tatenuma, K.; Yabuta, T.; et al. Activated Carbon Impregnated with Elementary Iodine: Applications against Virus- and Bacteria-Related Issues. C 2021, 7, 86. https://doi.org/10.3390/c7040086
Natori Y, Kinase Y, Ikemoto N, Spaziani F, Kojima T, Kakuta H, Fujita J, Someya K, Tatenuma K, Yabuta T, et al. Activated Carbon Impregnated with Elementary Iodine: Applications against Virus- and Bacteria-Related Issues. C. 2021; 7(4):86. https://doi.org/10.3390/c7040086
Chicago/Turabian StyleNatori, Yuri, Yoshiaki Kinase, Norihiro Ikemoto, Fabio Spaziani, Tsutomu Kojima, Hitomi Kakuta, Junko Fujita, Kazuyuki Someya, Katsuyoshi Tatenuma, Toshiyo Yabuta, and et al. 2021. "Activated Carbon Impregnated with Elementary Iodine: Applications against Virus- and Bacteria-Related Issues" C 7, no. 4: 86. https://doi.org/10.3390/c7040086
APA StyleNatori, Y., Kinase, Y., Ikemoto, N., Spaziani, F., Kojima, T., Kakuta, H., Fujita, J., Someya, K., Tatenuma, K., Yabuta, T., Takakuwa, H., & Otsuki, K. (2021). Activated Carbon Impregnated with Elementary Iodine: Applications against Virus- and Bacteria-Related Issues. C, 7(4), 86. https://doi.org/10.3390/c7040086
